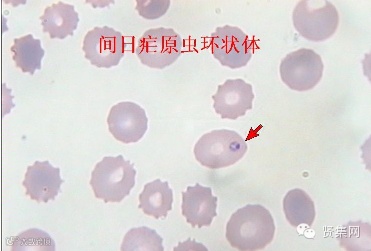

疟原虫可以入侵人类的红细胞并且干扰细胞的正常功能,近日有科学家开发了一种可以“哄骗”疟原虫模拟人类细胞膜的微型纳米结构,该研究或可帮助开发治疗疟疾及其它感染性疾病的新型疗法和疫苗。
研究者利用纳米模拟技术打断了疟原虫的正常循环,同时还设计并检测了这种宿主细胞膜纳米模拟结构的性能。为了开发这种模拟化的细胞膜,研究人员也设计了一种新型步骤来制造小型的人工气泡,其可以作为细胞受体处于细胞表面,而这样的携带水溶性宿主受体的多聚体小囊泡可以通过两种不同的成块共聚物的混合物来制备,在水溶液中这种模拟的纳米细胞膜可以进行自发组装。
通常情况下,疟原虫可以在进入机体48小时后破坏宿主红细胞的功能,随后就会继续感染新的红细胞,在感染阶段疟原虫必须结合特殊的宿主细胞受体。在这项研究中,研究人员利用荧光和电子显微镜技术检测了纳米细胞膜结合疟原虫的相互作用,可以结合从细胞中外流的疟原虫,进而阻断其侵入到别的未感染的细胞中。研究者表示,相比水溶性的细胞受体来讲,这种纳米模拟结构在降低疟原虫感染上是前者的100倍。换句话说,为了阻断疟原虫的感染需要利用100倍浓度的水溶性受体才可以完全阻断。
最后研究者说道,该项研究为后期开发治疗疟疾的新型替代疗法和疫苗提供了新的研究思路和希望,由于当前其它许多病原体也会利用相同的细胞受体来进行侵袭,因此研究人员开发的新型纳米模拟技术或将帮助治疗其它更多的感染性疾病。
我们的使命:科技贤者云集于“贤集网”这个平台,合作与交流让技术不再有领域的局限!合作与交流让中国不同区域的科技水平迅速得到巨大的提升和发展!
我们的口号:技术赚钱、企业省钱。技术有难题,赶快上贤集!

